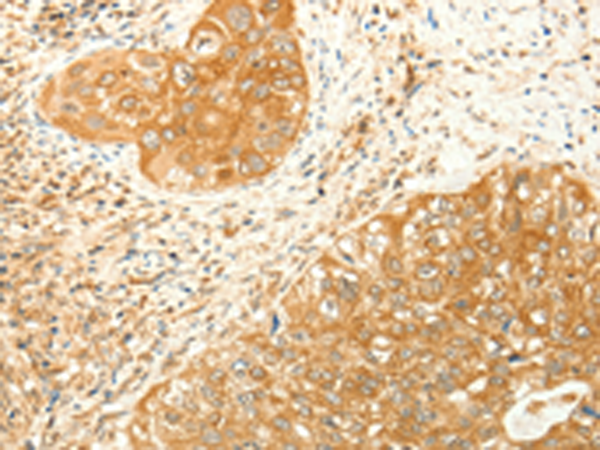

中文名稱: 兔抗RARRES1多克隆抗體
英文名稱: Anti-RARRES1 rabbit polyclonal antibody
別 名: TIG1
相關(guān)類別: 一抗
儲 存: 冷凍(-20℃)
宿 主: Rabbit
抗 原: RARRES1
反應(yīng)種屬: Human
標(biāo) 記 物: Unconjugate
克隆類型: rabbit polyclonal
技術(shù)規(guī)格
|
Background: |
This gene was identified as a retinoid acid (RA) receptor-responsive gene. It encodes a type 1 membrane protein. The expression of this gene is upregulated by tazarotene as well as by retinoic acid receptors. The expression of this gene is found to be downregulated in prostate cancer, which is caused by the methylation of its promoter and CpG island. Alternatively spliced transcript variant encoding distinct isoforms have been observed. |
|
Applications: |
ELISA, IHC |
|
Name of antibody: |
RARRES1 |
|
Immunogen: |
Synthetic peptide of human RARRES1 |
|
Full name: |
Retinoic acid receptor responder (tazarotene induced) 1 |
|
Synonyms: |
TIG1 |
|
SwissProt: |
P49788 |
|
ELISA Recommended dilution: |
5000-20000 |
|
IHC positive control: |
Human cervical cancer and Human colon cancer |
|
IHC Recommend dilution: |
100-300 |
購物車
幫助
021-54845833/15800441009
